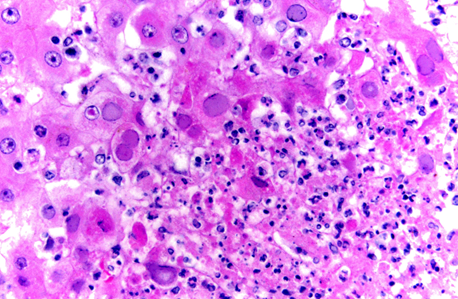
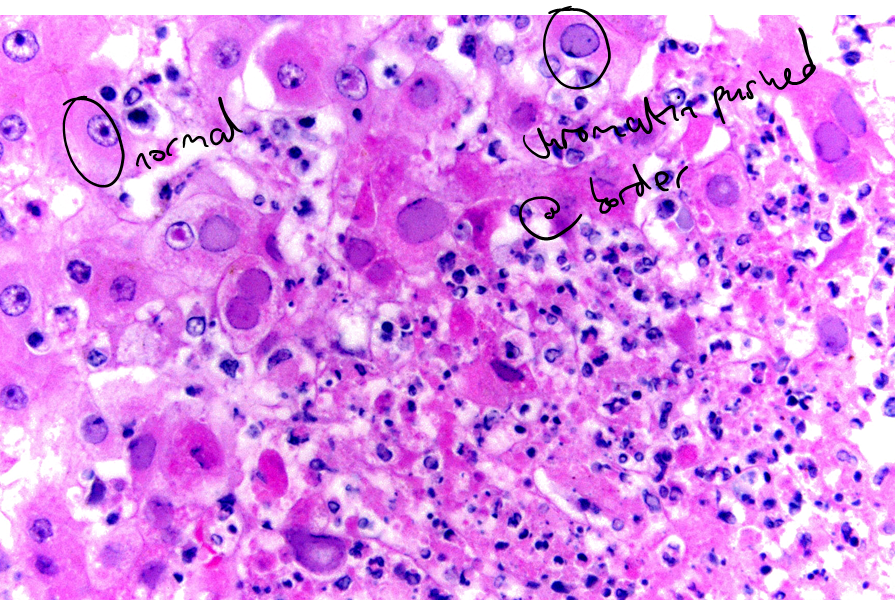

Skin pathology 2
1/76
There's no tags or description
Looks like no tags are added yet.
Name | Mastery | Learn | Test | Matching | Spaced | Call with Kai |
|---|
No analytics yet
Send a link to your students to track their progress
77 Terms
What bacteria causes impetigo?
Staphylococcus spp usually
In what species is impetigo common in?
Dogs but also reported in cats, cattle, pig, sheep and goat
Describe the pathogenesis of impetigo
Local proliferation of bacteria usually in association with other predisposing causes (cutaneous abrasions, poor nutrition) ; in puppies (dog) it occurs for no apparent reason
Describe the gross and histological presentiation of impetigo?
Erythematous (red) papules, forming then pustules

Neutrophilic pustules with intra-lesional bacteria NOT involving hair follicles
Acantholysis possible

What is the main Ddx of impetigo?
Pemphigus
What bacteria causes greasy pig disease/ exudative epidermitis?
Staphylococcus hyicus subsp. hyicus
In what animals does greasy pig disease occur?
Mostly young (5-35 days)
High morbidity and mortality
What is the pathogenesis of greasy pig disease?
Bacteria secrete exfoliative toxins (Exh) which digest intercellular proteins between keratinocytes
How does greasy pig disease present grossly?
Accumulation of greasy brown exudate in multiple body locations (acute form) which then dried out, forming crusts with multifocal erythema (chronic)

How does greasy pig disease present histologically?
Hyperkeratosis (both ortho and para)
Neutrophilic pustules with intra-lesional bacteria
Neurtrophilic dermatitis


^bacteria can be seen (basophilici stippling)
What agent causes dermatophilosis?
Dermatophilus congolensis (gram +ve coccoid bacterium able to produce branching filaments)

In what species is dermatophilosis mostly found in?
Mostly ruminants also horses, most common in hot humid tropics and subtropics
What is the pathogenesis of dermatophilosis?
Skin trauma and prolonged wetting
Allow bacteria to proliferate and cause disease
Continuous cycle of invasion of epidermis, inflammation, keratinocytes prolif.
How does dermatophilosis present grossly?
Papules, pustules forming coalescing crusts

How does dermatophilosis present histologically?

Alternating layers of parakeratotic and orthokeratotic keratin
Epidermal (and dermal) mixed inflam cells (mostly neutrophils)
Characteristic intra-epidermal bacteria
What agents cause deep pyoderma?
Staphylococcus spp. most commonly (also Streptococcus spp., Corynebacterium spp, Pseudomonas spp.)
What is the pathogenesis of deep pyoderma?
Bacterial infection and spread in the deeper integumentary structures (deep dermis, subcutis)
Opportunistic infection.
What is the gross lesion of deep pyoderma?
Very variable (both lesion and location)
Gross lesions include dark red raised nodules, oedema, hemorrhagic bullae, draining tracts, abscesses, purulent or serosanguineous exudate that dries to form crusts, and necrosis


How does deep pyoderma present histologically?
Folliculitis , furunculosis and dermatitis (usually neutrophilic)
What are the features of abscesses and cellulitis?
Caused by numerous bacteria
More common in large animals and cats —> fight wounds
What is the pathogenesis of abscesses and cellulitis?
Colonization of bacteria of deeper skin part.
Pyrexia and lymphadenomegaly often present.
Opportunistic.
How does abscesses and cellullitis present grossly?
Nodular accumulation of pus within skin (abscess) to diffuse dermal/subcut suppuration (cellulitis)
Common fistulae and skin necrosis.

How do abscesses and cellulitis present histologically?
Abscess —> Well demarcated accumulations of neutrophils and/or necrotic debris

Cellulitis —> Poorly demarcated extensive neutrophilic to pyogranulomatous dermal and subcut inflam

Which aetiological agent causes skin granuloma (granulomatous dermatitis)?
Actinomycetes (Actinomyces and Nocardia) and Mycobacterium
What are the features of skin granuloma?
All animals
Grow slowly
Colonisation of bacteria of deeper skin part (opportunistic)
How does skin granuloma present grossly?
Identical to abscesses and cellulitis (distinguishable only via histology)


How do skin granulomas present histologically? Difference between pyogranuloma and granuloma
Pyogranulomatous dermatitis and panniculitis with bacteria embedded within Splendore hoeppli material (actinomyces, nocardia)


Granulomatous to pyogranulomatous dermatitis with central caseous necrosis (Myobacterium = ZN stain to identify)


How can virus and bacteria be interlated in skin disease?
Damage from viruses gives rise to opportunistic bacteria
What are the three typical lesions that viruses can induce?
Ballooning degeneration (non-specific)

Vescicle (non-specific)

Inclusion bodies (specific!!)

What are the three generalities of virus and their features?
Poxviruses
DNA viruses w/ high epitheliotropism, numerous skin diseases
Intracytoplasmic inclusion bodies

Herpesvirus
DNA responsible for few primary skin diseases and occasional cutaneous involvement in systemic
Intranuclear inclusion bodies
Papillomavirus
Proliferative disease of squamous epithelia
No inclusion bodies

What is the disease progression of a "Pock" lesion (Poxvirus)

Some stages are more prevalent in different diseases
What dx does this image show?

Bovine papular stomatitis
What dx does this image show?

Pox virus in monkey —> made up of vesicles & pustules
What dx does this image show?

Avian pox virus —> has more crusts than pox virus and bovine papular stomatitis
What aetiological agent causes orf (contagious pustular dermatitis)?
A poxvirus genus parapox —> orf virus
What animals does orf affect?
Young sheep and goats ; less frequently other animals (including lilehs); highly contagious but almost never lethal unless infected by scratching and leaving for agesssssssss and then having an allergic reaction to penicillin innit bruv
What is the pathogenesis of orf?
Infects keratinocytes, makes them proliferate with inflam & crust formation
How does orf present grossly?
Typical pox lesion around lips, muzzle and eye showing great degree of epidermal proliferation and crust


How does orf present histologically?
Spongiosis
Micropustules
Epidermal hyperplasia
Intra-cytoplasmic inclusion bodies

What aetiological agents causes cowpox?
Poxvirus with genus orthopox —> cow pox virus
What animals does cowpox affect?
Felids, rodents (reservoirs), cattle, humans
What is the pathogenesis of cowpox?
Infect keratinocytes
Viraemia
In felids during viraemia might affect lung —> could be fatal
Wide spread skin lesions
How does cowpox present grossly?
Crusts and ulcers on anywhere of the skin (felids)

Papules, nodules and ulcers on teats(cow)

How does cowpox present histologically?
Ulcers covered by fibrino-necrotic exudate.
Intra-cytoplasmic eosinophilic inclusion bodies within keratinocytes

What aetiological agent causes herpesvirus in a cat?
Felid herpes virus 1
What is the pathogenesis of felid herpesvirus
Infects skin
Not usually associated with resp form
How does herpesvirus in cats present grossly?
Vesicles, crusts and ulcers and frequently on the face or nasal planum —> can be persistent or recurrent

How does herpesvirus in cats present histologically?
Ulcerative and eosinophilic dermatitis
Large intra-nuclear inclusion bodies
What is the pathogenesis of papillomaviruses?
Infects basal layer of keratinocytes only
Replicated only in well differentiated keratinocytes
Usually increase proliferation of keratinocytes
Define papilloma
1-2 cm wart-like, filiform (long, thin, hair-like), exophytic (raised), and hyperkeratotic mass composed of hyperplastic epidermis supported by dermal stalks


What can papillomaviruses induce?
Other types of neoplasms as viral plaques
In situ carcinoma
Squamous cell carcinoma
What is the difference between viral and non viral papillomas?
Viral
Younger animal
Mass can wane away, stay stable or progresses to squamous cell carcinoma
Presence of koilocytes = abnormal squamous ep. cells, enlarged nucleus (cytopathic effect)

Non viral
Older animals
Mass remains stable usually
Absence of koilocytes
What viral agent can cause equine sarcoids?
Bovine papillomavirus 1, 2 & 13
How do equine sarcoids present grossly?
Nodules showing variable size and features (ulceration, crust formation)
Most frequent in head, limbs and trunks (most frequent skin tumour in horses)


How does an equine sarcoid present histologically?

Biphasic tumour (epithelial and dermal component)
Epithelial is epidermal hyperplasia with hyperkeratosis (might be absent)
Dermal haphazardly arrranged bundles of atypical fibroblasts
No inclusion bodies, no koilocytes!!
(no specific IHC marker)
What are the three generalities of fungi and their features
Cutaneous mycosis
Colonise non-living cornified layers of skin, hair & claws
Need keratin
Subcutaenous mycosis
Involve skin and subcut tissues
Wide variety of opporunistic agents (saphrophytic fungi)
Infection usually remains @ site of entry
Sytemic
Most rare, skin involvement is secondary to systemic spread
What agents cause dermatophytosis (ring worm)?
Trichophyton and Microsporum (numerous species)
Cat and dog —> Microsporum canis
Horse cattle and ruminants —> Trichophyton verrucosum (zoonotic)
What is the pathogenesis of dermatophytosis (ringworm)?
Usually individual are resistent but predisposing causes (young age, stress, malnutrition) and environmental factors might allow colonisation of keratin
Only able to colonise keratin, cannot extend below dermis
Every species has its own reservoirs species
M. canis —> cat
T. verrucosum —> cattle
Usually non-pruritic
How does dermatophytosis present grossly?
Expanding circular patches of scaling and alopecia



How does dermatophytosis present histologically?
Orthokeratotic hyperkeratosis
Folliculitis and furunculosis
Hair shafts containing hyphae and fungal spores


What aetiological agent causes leishmaniasis?
Leishmania infantum
affects dogs & can affect humans
How is leishmania transmitted?
By Phlebotomus sp. sandflies
'Shuttled' intracytoplasmically by macrophages where they replicate
What are the forms of leishmania?
Cutaneous form occurs in 80% of cases
or visceral form
Immune response will determine outcome of infection and most notably whether there is a strong Th1 (lots of macrophages to contain infection) or a strong Th2 response (lots of abs prroduced = not protective against infection i.e. more harmful)
How does leishmania present grossly?
Extremely variable. Key features are scaling and alopecia


How does leishmania present histologically?
Extremely variable
Ortho and parakeratotic hyperkeratosis and marked dermal presence of macrophagic inflammatory infiltrate, together with lymphocytes + plasma cells.
Amastigotes presence

What causes sarcoptic mange?
Sarcoptes scabiei (burrowing mite)

affects numerous domestic (common in dogs, pigs & goats) & wild mammals (incl. humans)
What is the pathogenesis of sarcoptic mange?
Live, feed and reproduce on host epidermis
Direct mechanical damage and irritant effects from excreta and saliva which also causes allergic reaction
Intensely pruritic
How does sarcoptic mange present grossly?
Erythematous and crusted papules progressing to larger crusts and finally to lichenification and alopecia.
Distribution of lesions varies according to the species affected and the clinical form.

How does sarcoptic mange present histologically?
Intra-lesional mites and ova present (not as good as doing a scrape)


Severe epidermal hyperplasia
Ortho and patchy para keratosis
Spongiosis
Inflammatory infiltrate within epidermis and eosinophilic pustules
What causes demodectic mange?
Demodex spp
affects mostly dogs

What is the pathogenesis of demodectic mange?
Live, feed and reproduce on host hair follicle, feeding onto sebum & epidermal.
Normal commensal on skin in low numbers
Local/systemic immunodef consisered responsible for prolif of mite & inflam
What are the two forms of demodectic mange and how do they present grossly?
Localised —>small erythematous and scaly alopecic lesions, usually in extremities and face
Generalised demodicosis —> greater diffusion, formation of comedones, nodules also commonly extend to multiple paws, form more severe and commonly leads to bacterial invasion


How does demodectic mange present histologically?
Intrafollicular mites with characteristic cigar shape

Perifollicular mixed dermatitis
Possible furuncolusis
Abscess formation due to bacterial breech
What causes myiasis?
Fly larvae infecting aniamls
Lucilla (blowlflies) in sheep
Hypoderma in cattle
Cuterebra in rodents and cats
Describe the pathogenesis of myiasis
Adult fly depose eggs on the skin of the host, from where the larva penetrates it.
While some of them remains in the invasion site, other might migrate to distant sites (depending on the life cycle)
They colonise and develop within cyst-like dermal structures with a central pore for breathing emerge from the pore and pupate in the environment.
How does myiasis present grossly and histologically?


Recall the relevant stains in histopathlogy?
